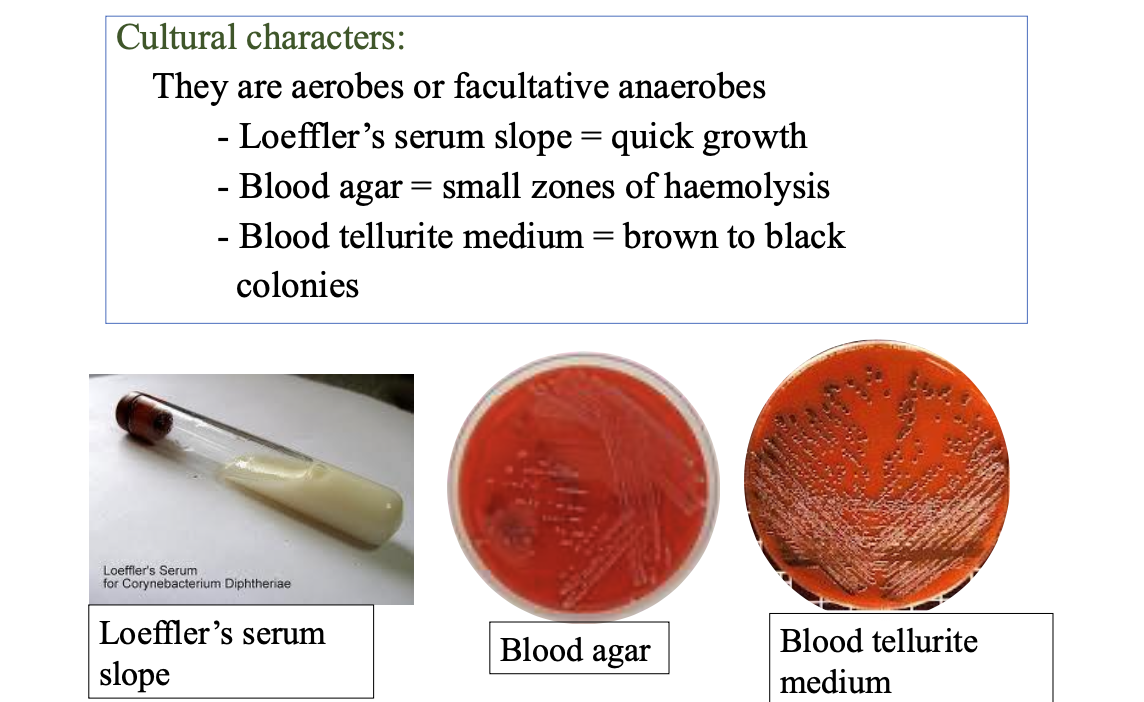
knowt flashcard image

Gram positive bacterias
1/35
Earn XP
Description and Tags
For yadanar
Name | Mastery | Learn | Test | Matching | Spaced | Call with Kai |
|---|
No study sessions yet.
36 Terms
Genus Staphylococcus (Morphology and identification)
Gram-positive spherical cells arranged in
grapelike irregular clusters
Test that differentiates the staphylococci from the
streptococci.
Catalase test
Test that differentiates Staphylococcus aureus from Staph.
epidermidis and Staph. saprophyticus.
Coagulate test
Staphylococci virulence factors (Enzymes)
i) Catalase converts hydrogen peroxide into water and oxygen.
ii) Coagulase triggers blood plasma clotting, allowing bacteria protection
from immune defenses.
iii) Streptokinase dissolves blood clots. Bacteria trapped within a clot can
free themselves and spread the infection
iv) Hyaluronidase dissolves the ”cement“ that holds together the
cells that line the intestinal tract, then invade deeper cells within
the intestinal tissues
Staphylococci virulence factors (Toxins)
v) Exotoxins
- α, β, δ and γ toxins lysing white blood cells, necrosis and
severe inflammation
vi) Panton-Valentine leukocidin:
• acts on the white blood cell membrane.
vii) Exfoliative Toxins
# Epidermolytic toxin A and B cause generalized
desquamation of the epidermis.
viii) Toxic Shock Syndrome Toxin
It is associated with fever, desquamative skin rash, shock and
multisystem involvement.
ix) Enterotoxins
(A–E, G–J, K–R and U, V)
an important cause of food poisoning
Infections caused by Staphylococcus aureus

Toxin associated diseases caused by Staphylococcus aureus
Scalded skin syndrome
Bullous exfoliation
Toxic shock syndrome
Food poisoning
Staph. epidermidis normal flora and related infections
the normal flora of the human skin respiratory and gastrointestinal tracts.
may infect orthopedic or cardiovascular prostheses or cause disease in immunosuppressed persons.
Staph. saprophyticus related infections
urinary tract infections in young women
Genus streptococcus classification

Genus streptococcus virulence factors

Infections caused by Streptococcus pyogenes (Cutaneous evasion)

Streptococcus pyogenes local infection
Streptococcal sore throat (pharyngitis)
Streptococcal pyoderma (impetigo)
Streptococcus pyogenes invasion
1) Streptococcal toxic shock syndrome
2) Scarlet fever
Streptococcus pyogenes (Post streptococcal diseases)

Viridans streptococci and their normal flora and related infections
normal flora of the upper respiratory tract
may reach the bloodstream as a result of trauma and are a principal cause of endocarditis on abnormal heart valves.
Strep. mutans contributes to the genesis of dental caries.
Streptococcus pneumoniae and its infections
Pneumococcal pneumonia
Bacteremia from pneumonia can cause meningitis endocarditis and septic arthritis
Streptococcus agalactiae and its infections and normal flora
part of the normal vaginal flora in 5-25% of women.
neonatal sepsis, meningitis or respiratory distress syndrome.
bacteremia, skin and soft tissue infections, respiratory infections and genitourinary infections in adults.
Enterococci and their infections and normal flora

Bacillus anthracis and anthrax mode of transmission

Bacillus anthracis and anthrax virulence factors

Depends on the portal of entry three types of anthrax
Cutaneous anthrax
GI anthrax
Pulmonary anthrax
Cutaneous anthrax
Entry of spores (exposed areas of arms and hands or injured skin)
Pruritic papule- vesicle-necrotic ulcer- edema-eschar
Lymphangitis and lymphadenopathy and systemic signs and symptoms of fever, malaise and headache may occur.
May lead to sepsis

Pulmonary anthrax (inhalation anthrax)
Substernal pain
Haemorrhagic pleura effusion
Sepsis
Potent toxin - can be use in biologic warfare

GI anthrax

Lab diagnosis of anthrax

Bacillus cereus related infection

Corynebacterium diphtheriae Morphology and identification
Gram positive club-shaped bacilli arranged in Chinese
letter appearance.
Corynebacterium diphtheriae culture characters
Corynebacterium diphtheriae virulence factors and clinical features
Virulence factors -bacteria establishment in the throat.
Production of exotoxin (diphtheria toxin)
(necrotizing and neurotoxic effects)

Corynebacterium diphtheriae toxin complication

Clostridium tetani morphology and source
Gram positive bacillus with terminal round spores (drum stick appearance)
Commonly found in soil, hospitals and intestines of man and animal
Clostridium tetani virulence factors

Clostridium tetani mode of transmission and clinical features

Clostridium tetani lab diagnosis treatment and prevention

Tetanus neonatorum
From infected umbilical cord
